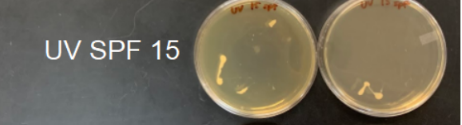

Write down one observation that you have about the Wild-Type Yeast.
Some things you can mention: yeast growth on the plate (a lot, a little, no growth)
Write down one observation that you have about the UV sensitive yeast with SPF 15
Some things you can mention: yeast growth on the plate (a lot, a little, no growth)
Write down one observation that you have about the UV sensitive yeast with SPF 50
Some things you can mention: yeast growth on the plate (a lot, a little, no growth)

Write down one observation that you have about the UV sensitive yeast that was covered in tin foil
Some things you can mention: yeast growth on the plate (a lot, a little, no growth)

Write down one observation that you have about the UV sensitive yeast that was not covered (fully exposed to the UV radiation)
Some things you can mention: yeast growth on the plate (a lot, a little, no growth)

Write down one observation that you have about all four UV sensitive plates.
Some things you can mention: yeast growth on the plate (a lot, a little, no growth)
The hypothesis for the lab is If UV sensitive yeast is covered with SPF 15, SPF 50, or fully covered, then the yeast fully covered will have the most growth because UV rays kill the yeast cells. Was the hypothesis supported?
Your Conclusion Needs the Following Information. Use the sentence starters:
The hypothesis is (supported/not supported) because….
The plate that has the most yeast is ….
The plate that has the least amount of yeast is ….
Provide Reasoning:
Explain why the plates had a lot or little growth
Was the hypothesis supported? Provide two pieces of evidence from the lab to explain your reasoning? YOU NEED 2 pieces of evidence
Start with the sentence:
The hypothesis is (supported or not supported) because...